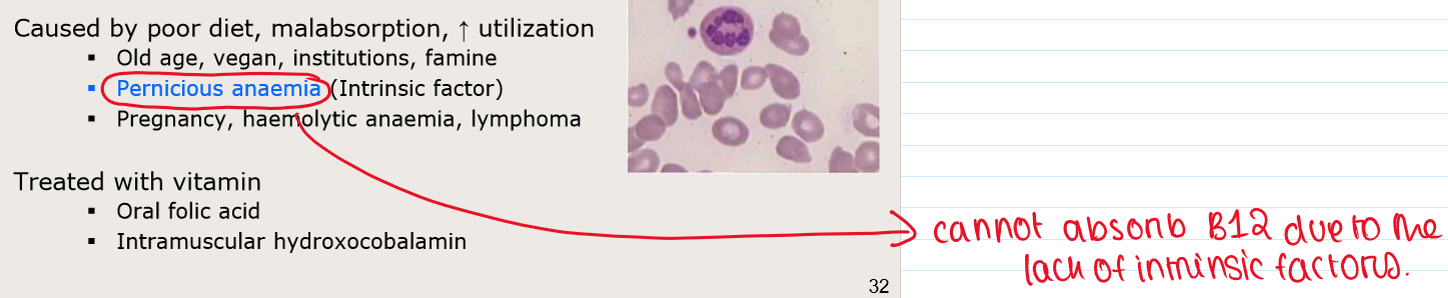

1/40
Looks like no tags are added yet.
Name | Mastery | Learn | Test | Matching | Spaced | Call with Kai |
|---|
No study sessions yet.
What is blood gas transport?
Haemoglobin (Hb) binds O2 in lungs (where PO2 is high) and unbinds it in tissues (where PO2 is low)
Hb moves CO2 in opposite direction
Cooperativity and chemical allosteric effects —→ more O2 is bound in lungs and is deposited in tissues
How is oxygen carried in blood?
Poorly soluble in plasma – normal arterial blood carries 70X more O2 on Haemoglobin (Hb in RBCs) than dissolved directly in plasma
Hb is needed to carry O2
Thus, it is possible for arterial PaO2 to be normal but hypoxia to occur (b/c there is no Hb to carry O2)
Why do you need O2?
Oxidative Respiration Produces More Energy
muscle: C6H12O6 + 6 O2 —→ 6 CO2 + 6 H2O + ~36 ATP
In RBCs without mitochondria (anaerobic glycolysis):
C6H12O6 —→ 2 lactate + 2 ATP
How is oxygen delivered to tissues by Hb?
Hb must bind O2 (to carry it to tissues)
Hb must ALSO RELEASE the O2
Binding of O2 to Hb must be weak enough to be reversible
There need to be mechanisms at the muscles for reducing O2 affinity to Hb
What is cooperativity of Hb?
The phenomen where binding an oxygen molecule to one heme group increases the affinity of the other heme groups for oxygen, making it easier for them to bind.
What is the structure of Hb?
Each subunit has a small haem group (616 Da) + a large globin peptide (17,000 Da)
Haem is coloured, contains one Iron atom, and is site of O2 binding
Peptide/protein component = “globin”
Hb in adults
2 alpha subunits + 2 beta subunits (4 subunits = tetramer)
Also called “maternal Haemoglobin”
Foetal Hb
2 alpha subunits + 2 gamma subunits
Adults have a small percentage of HbF
HbF binds O2 more strongly than HbA
what is Haem group?
1) Haem is a porphyrin ring
2) They are rigid, 2 dimensional, and highly coloured due to sharing of electrons
•Hence red and blue colour
•Not due to Iron
3) conjugated to iron ion
Ferrous (Fe2+)
4) O2 molecule binds to the Fe2+
Without oxidising it
What is the Bohr Effect?
INCREASE blood carbon dioxide level —→ DECREASE affinity of Hb for O2
DECREASE blood pH (i.e. acidic) —→ DECREASE affinity of Hb for O2
CO2 & H+ bind Hb but at a different site from O2 (ALLOSTERIC SITE)
How is CO2 transported in blood?

Haemoglobin Saturation Curve

Why are saturation curves important?
1) The health of muscle and peripheral tissue depends on the local pO2 (i.e. the concentration of free O2 in muscle cells)
•The muscle pO2 is in equilibrium with capillary pO2
2) If Hb saturation is in the middle of the curve, O2 will not be released UNLESS local tissue pO2 is further left (and down) on the saturation curve
3) So Hb can arrive with lots of O2 molecules from the lungs, but it will not release enough O2 unless local pO2 is low COMPARED TO THE O2 SATURATION ON THE CURVE
Thus, local tissue pO2 will have to drop to get delivery of O2
4) Left-shifting of curve means more O2 stays on Hb; less O2 is delivered
What is SpO2?
the nominal saturation of Hb in peripheral tissue as measured by a pulse oximeter on the finger.
peripheral measure, so it is influenced by local ischaemia
How is oxygen affinity regulated?
R (rightward shift) —→ DECREASE affinity for O2
CO2 —→ rightward shift (R)
H+ —→ rightward shift
Cl- —→ rightward shift
2,3-DPG —→ R (Diphospho-glycerate Bis-phospho-glycerate
Muscle activity encourages Hb to release O2
What is 2,3-DPG?
1) 2,3 diphosphoglycerate
a/k/a 2,3 bis phosphoglycerate,
2,3 BPG
2) Binds to Hb
3) Lowers affinity of Hb for O2
4) 2,3-DPG found in erythrocytes at 5 mM
5) Tiny molecule compared with Hb
6) causes a right shift in affinity
How does 2,3-DPG affect Hb F?
1) foetal Hb has low affinity for 2,3-DPG
versus maternal blood
2) Thus Hb F has a higher binding affinity for oxygen than Hb A
Because HbF is less likely to be bound to 2,3-DPG
O2 saturation curves for maternal and foetal haemoglobin

What happens in active muscles?
1) O2 is low
2) CO2 is high
Blood is slightly acidic
Due to CO2 and lactic acid
Temperature is higher
3) There is myoglobin (left-shifted saturation vs Hb)
4) All the above contribute to causing the following:
O2 leaves the Hb (cooperativity)
CO2 and H+ bind to Hb – shifts Hb saturation to right
HCO3- leaves RBC —→ plasma,
Cl- leaves plasma —→ enters RBC (Cl- shift)
How is breathing controlled by O2, CO2 AND H+?

What is the structure of RBC?
Biconcave disc
Anucleate, lack organelles
7 um diam, 2 um height
Contain haemoglobin
What is the function of RBC?

How many RBCs are there?

What is erythropoiesis?
Erythropoiesis = development/production of RBCs
After birth: bone marrow only
After age 20: primarily central bones (e.g. vertebrae)
Where does erythropoiesis happen in the embryo?
Liver
Spleen
Lymph nodes
Yolk sac
What are the stages of development from stem cells?

Haematopoiesis

Erythropoiesis - RBC production

What is Erythropoietin (EPO)?
A cytokine / hormone that drives erythropoiesis
What are reticulocytes?
1) Immature RBC precursor
Before complete extrusion of nucleus + organelles
2) Lasts for 2 days in blood
Then becomes definitive RBC
How can reticulocyte count be used as a diagnostic tool in anaemia?
1) Indicator of bone marrow activity
2) High in haemolytic anaemias (homeostatic response)
3) Low when erythropoiesis is low
4) Machine counts cells and detects those with basophilic material (eg DNA) in them
What is methaemoglobinaemia?
1) Disorder: Hb cannot transport O2
Example: PaO2 appears normal but O2 delivery is low
Dyspnoea, pallor/cyanosis
2) Fe in haemoglobin is oxidized (Fe3+)
Instead of usual ferrous (Fe2+)
What causes methaemoglobinaemia?
Congenital globin mutations (Hb M)
Hereditary decrease of NADH
Various toxic substances, poisons and drugs
Carbon Monoxide poisoning?
1) Hb cannot transport O2
Due to:
CO Displaces O2 from Hb
O2 and CO have same binding site
2) Affinity for CO is 250X stronger
Low levels of CO can completely displace most O2
PO2 dissolved in blood remains normal
Lethal
3) blood turns bright red (this is opposite to cyanosis!)
Brain affected first = disorientation
Treatment: 100% O2 (O2 replaces CO by mass action)
What is polycythaemias?
INCREASE Number of RBCs (PCV)
INCREASE Viscosity of blood
“Clog” blood vessels
What is physiological polycythaemia?
Due to living at high altitude
What is polycythaemia vera?
Neoplasm
Often asymptomatic
Risk of thrombotic events
No cure, treat with venesection
All ages, INCREASE with age
Usually caused by mutated JAK2 kinase
Unknown why JAK2 mutates
What are iron requirements fro RBC production?
1) 65% of all iron in adult is in RBC haemoglobin
2) Fe stored intracellularly as Ferritin & Haemosiderin (30%)
3) Fe stored in reticulo endothelial system:
Liver, spleen, erythrocytes, bone marrow, macrophages/monocytes
4) depleting all iron from stores leads to anaemia (microcytic hypochromic)
5) Only small % dietary Iron absorbed
High Iron concentration in red meat
Iron loss ~1 mg/day
More for pregnancy, menstruation, peptic ulcers
5) Iron deficiency can —> iron deficient anaemia
Microcytic, hypochromic
Why is Vitamin B12 and Folic Acid important?

What are the causes and treatment of vitamin B12 and Folic Acid deficiency?
Mnemonic for Anaemias
1) Iron deficiency: hypochromic microcytic anaemia
The cells keep dividing but they cannot fill up with Hb
2) Folic acid or B12 deficiency: megaloblastic anaemic
The cells keep filling up, but they cannot divide fast enough